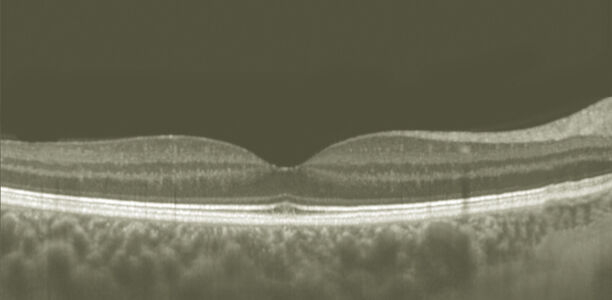
Bild zu Typ-1-Diabetes - Neurodegenerative Veränderungen der Retina bei pädiatrischen Patienten mit Typ-1-Diabetes

Zahlreiche metabolische Erkrankungen gehen mit ophthalmologischen Veränderungen einher, welche jedoch über lange Zeit symptomlos bleiben und im Regelfall erst erkannt werden, wenn das Sehvermögen bereits eingeschränkt ist. In diesem Zusammenhang nimmt die Retina als ein vaskularisiertes neuronales Gewebe und Teil des Zentralnervensystems eine besondere Rolle ein. Ihre Zugänglichkeit ermöglicht es, vaskuläre und neurodegenerative Veränderungen mit Hilfe der optischen Kohärenztomographie (OCT) als einem nicht invasiven Verfahren darzustellen.
Dieser Beitrag steht nur registrierten Benutzern mit Berufsverifizierung zur Verfügung. Jetzt anmelden.Typ-1-Diabetes
Neurodegenerative Veränderungen der Retina bei pädiatrischen Patienten mit Typ-1-Diabetes
© Augenheilkunde Universitätsmedizin Rostock
© Augenheilkunde Universitätsmedizin Rostock
